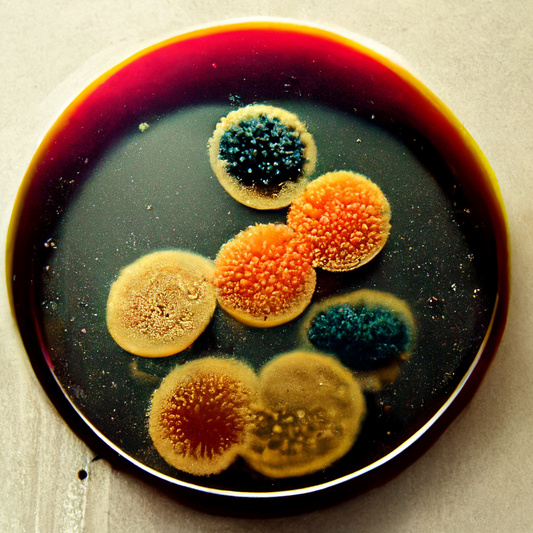

News

The Benefits of Tape Lifts for Mould Testing: A...
Introduction Mould can be a silent menace in our homes and offices, wreaking havoc on our health and the integrity of our buildings. Mould growth often goes unnoticed until it...
The Benefits of Tape Lifts for Mould Testing: A...
Introduction Mould can be a silent menace in our homes and offices, wreaking havoc on our health and the integrity of our buildings. Mould growth often goes unnoticed until it...

Why You Should Trust Skilled Labs for Accurate ...
Introduction It is essential to have your home tested for mould and mycotoxins after water damage because moulds have the potential to cause health problems. Moulds produce allergens, irritants,...
Why You Should Trust Skilled Labs for Accurate ...
Introduction It is essential to have your home tested for mould and mycotoxins after water damage because moulds have the potential to cause health problems. Moulds produce allergens, irritants,...

5 Factors Associated with Fungal Infection Risk
The majority of people who have fungal infections will not have any symptoms. Some people may experience the infection as a low-grade fever, headache, or body aches. Other people may...
5 Factors Associated with Fungal Infection Risk
The majority of people who have fungal infections will not have any symptoms. Some people may experience the infection as a low-grade fever, headache, or body aches. Other people may...

Fungi can be a sneaky menace and if you're not ...
The interstitial lung illness known as hypersensitivity pneumonia is characterised by an aberrant immune response to certain antigens found in a variety of organic particles like dust. Hypersensitivity pneumonia at...
Fungi can be a sneaky menace and if you're not ...
The interstitial lung illness known as hypersensitivity pneumonia is characterised by an aberrant immune response to certain antigens found in a variety of organic particles like dust. Hypersensitivity pneumonia at...

Why I want to talk about one of the biggest hea...
Mould and mycotoxin effects have been known for a long time. People started to study the effects on animals a lot. Then they did it with people too, but it...
Why I want to talk about one of the biggest hea...
Mould and mycotoxin effects have been known for a long time. People started to study the effects on animals a lot. Then they did it with people too, but it...
Are you looking for a natural way to inhibit da...
In a recent research report [1], adding apple cider vinegar to the growth medium resulted in anti-fungal activity comparable to that of nystatin against Candida spp. Vancomycin-resistant strains of S....
Are you looking for a natural way to inhibit da...
In a recent research report [1], adding apple cider vinegar to the growth medium resulted in anti-fungal activity comparable to that of nystatin against Candida spp. Vancomycin-resistant strains of S....